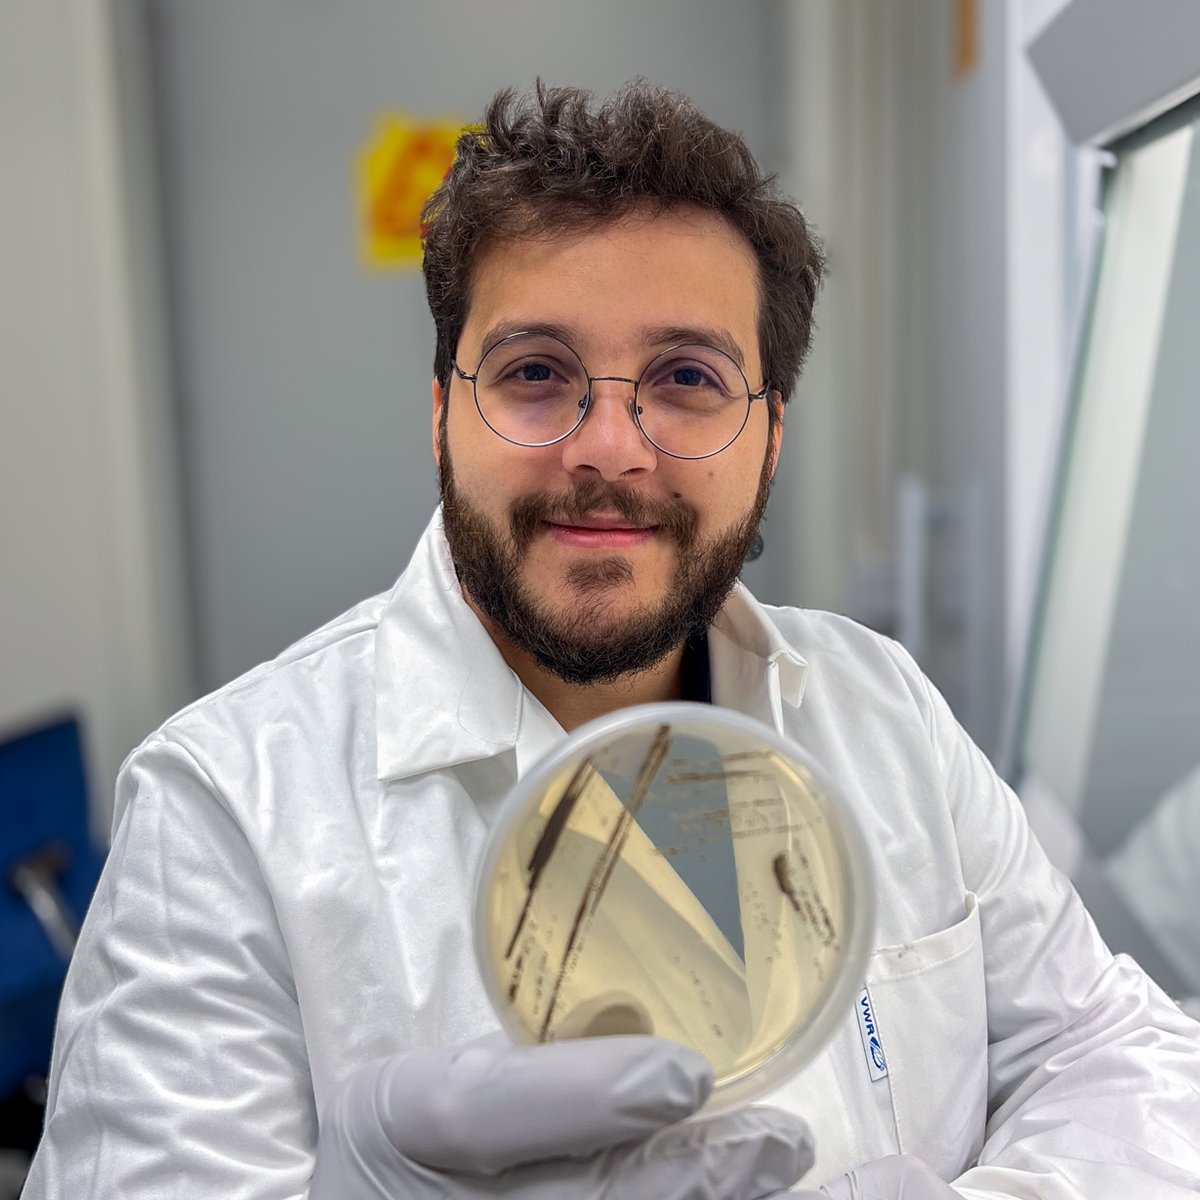
Alef dos Santos håller upp en petriskål

Interdisciplinary collaboration
Alef dos Santos research is part of an interdisciplinary project that brings together researchers from several departments within the Chemical-Biological Centre, KBC. His research is made possible through collaboration with scientists from the Department of Chemistry, the Department of Ecology and Environmental Sciences, and the Umeå Marine Sciences Centre, UMF.
The project is funded by Kempestiftelsen.